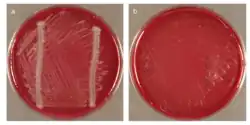

Chloroflexota
Chloroflexi
| |||||||
|---|---|---|---|---|---|---|---|
![]() | |||||||
| Classificação científica | |||||||
| |||||||
| Ordens / Famílias / Géneros | |||||||
| Ordem: Chloroflexales Família: Chloroflexaceae | |||||||
Introdução
Chloroflexaceae ou Chloroflexi são bactérias verdes não sulfurosas. Obtêm energia mediante fotossíntese. A sua denominação deve-se ao fato de possuírem um pigmento verde, que se encontra geralmente associado a estruturas membranosas internas chamadas clorossomas.
As bactérias deste grupo são tipicamente filamentosas e movem-se mediante deslizamento sobre superfícies. São aeróbios facultativas, mas não produzem oxigênio durante a fotossíntese; realizam fotossíntese anoxigénica. A sua via de fixação de carbono também difere da de outras bactérias fotossintéticas.
Bactérias do filo Chloroflexi, são comuns e abundantes em comunidades microbianas de vida livre [1] [2] [3] [4]. Uma razão para seu sucesso é sua diversidade metabólica; cepas cultivadas do filo incluem podem ser aeróbios termófilos, fotossintetizantes anoxígenos (apesar do nome “não sulfurosa”, essas bactérias usam H2S na fotossíntese), ou ainda crescer anaerobicamente utilizando compostos halógenos como fonte de energia [5].
Os representantes cultivados do filo são classificados em quatro classes pelo banco de dados de taxonomia do genoma [6], pela Cloroflexia e Ktedonobacteria principalmente aeróbias e pelas anaeróbias Anaerolineae e Dehalococcoidia [5].
Um dos principais representantes, Chloroflexus, é filamentoso, termofílico e cresce em associação com cianobactérias, dando origem à cor laranja-avermelhada de fontes termais.
História
Em 1987, Carl Woese dividiu as Eubactérias baseado na sequencia de RNA ribossomal 16S e agrupou os gêneros Chloroflexus , Herpetosiphon e Thermomicrobium em "bactérias e parentes verdes não-enxofre" [28][29], que foi temporariamente renomeada como "Chloroflexi" no primeiro volume do Manual de Bacteriologia Sistemática de Bergey [30].
Sendo um filo ramificação profunda, a sua classificação foi analisada no primeiro volume do Manual de Bacteriologia Sistemática de Bergey e incluiu uma única classe com o mesmo nome, a classe Chloroflexi [30]. Desde 2001 no entanto, novas classes foram criadas graças a espécies recém-descobertas, sendo o filo Chloroflexi é dividido em [31]:
- Chloroflexi Gupta et al. 2012
- Thermomicrobia Hugenholtz & Stackebrandt de 2004
- "Dehalococcoidetes" Hugenholtz & Stackebrandt de 2004
- Anaerolineae Yamada et al., 2006
- Caldilineae Yamada et al., 2006
- Ktedonobacteria Cavaletti et al., 2007 emenda. Yabe et al., 2010
Em relação à classe "Dehalococcoidetes ", o nome do marcador foi determinado por Hugenholtz & Stackebrandt, 2004 [32], depois de "Dehalococcoides ethenogenes", uma espécie parcialmente descrita em 1997 [33], sendo que a primeira espécie totalmente descrita foi a Dehalogenimonas lykanthroporepellens por Moe et al. 2009 [34].
Etimologia
O nome "Chloroflexi" é um Neolatin plural de "Chloroflexus", que é o nome do primeiro gênero descrito. O substantivo é uma combinação do grego chloros (χλωρός) [6], que significa "amarelo-esverdeado" e o latim flexus (do flecto) [7], que significa "dobrado" para significar "uma flexão verde" [8]. Deve ser, portanto, notar-se que a etiologia não é devida ao cloro, um elemento (ar ácido muriático deflogisticado) que foi confirmada como tal em 1810 por Humphry Davy e nomeado após a sua cor verde pálido. Outra filo com a mesma raiz é Chlorobi , enquanto Cyanobacteria tem as raízes cianobactérias (κύανος) que significa "azul-verde".
Filogenia
| ||||||||||||||||||||||||||||||||||||||||||||||||||||||||||||||||||||||||||||||||||||||||||||||||||||||||||||||||||||||||||||||||||||||||||||||||||||||||||||||||||||||||||||||||||||||||||||||||||||||||||||||||||||||||||||||||||||||||
Taxonomia
A análise genômica comparativa refinou a taxonomia da classe Cloroflexia, dividindo os Chloroflexales na subordem Chloroflexineae, consistindo das famílias Oscillachloridaceae e Chloroflexaceae, e da subordem Roseiflexineae, família Roseiflexaceae [9]. A taxonomia revisada foi baseada na identificação de um número de indels de assinatura conservada (CSIs) que servem como marcadores moleculares altamente confiáveis de ancestralidade compartilhada [9] [10] [11]. Apoio adicional para a divisão dos Chloroflexales em duas subordens são as diferenças observadas nas características fisiológicas, onde cada subordem é caracterizada por carotenóides distintos, quinonas e perfis de ácidos graxos que estão consistentemente ausentes na outra subordem [10] [11]. Além de demarcar fileiras taxonômicas, os CSIs podem desempenhar um papel nas características únicas dos membros dentro do clado. Em particular, uma inserção de quatro aminoácidos na proteína piruvato flavodoxina / ferredoxina oxidoredutase, uma proteína que desempenha um papel importante em organismos fotossintéticos, foi encontrada exclusivamente entre todos os membros do gênero Chloroflexus, e acredita-se que desempenhe um importante papel funcional [14].
Atualmente, taxonomia aceita segue a lista abaixo [20, 21, 22]:
- Ordem Chloroflexales
- Subordem Chloroflexineae
- Família Chloroflexaceae Trüper 1976 emend. Gupta et al. 2013
- Gênero Chloroflexus Pierson and Castenholz 1974
- C. aggregans Hanada et al. 1995
- C. aurantiacus Pierson and Castenholz 1974
- Gênero Chloroflexus Pierson and Castenholz 1974
- Família Oscillochloridaceae Keppen 2000 emend. Gupta et al. 2013
- Gênero Oscillochloris Gorlenko and Pivovarova 1989 emend. Keppen et al. 2000
- O. chrysea Gorlenko and Pivovarova 1989
- O. trichoides (ex Szafer) Gorlenko and Korotkov1989 emend. Keppen et al. 2000
- Gênero Chloronema Dubinina and Gorlenko 1975
- Chloronema giganteum Dubinina and Gorlenko 1975
- Gênero Oscillochloris Gorlenko and Pivovarova 1989 emend. Keppen et al. 2000
- Família Chloroflexaceae Trüper 1976 emend. Gupta et al. 2013
- Subordem Roseiflexineae
- Família Roseiflexaceae Gupta et al. 2013
- Gênero Roseiflexus Hanada et al. 2002
- Roseiflexus castenholzii Hanada et al. 2002
- Gênero Heliothrix Pierson et al. 1986
- Heliothrix oregonensis Pierson et al. 1986
- Gênero Roseiflexus Hanada et al. 2002
- Família Roseiflexaceae Gupta et al. 2013
- Subordem Chloroflexineae
- Ordem "Herpetosiphonales"
- Família "Herpetosiphonaceae"
- Gênero Herpetosiphon Holt and Lewin 1968
- H. aurantiacus Holt and Lewin 1968
- H. geysericola (Copeland 1936) Lewin 1970
- Gênero Herpetosiphon Holt and Lewin 1968
- Família "Herpetosiphonaceae"
Curiosidades
- Estima-se que o Chloroflexi dominará a comunidade microbiana de alguns sedimentos de fundos marinhos e também podem constituir 12% e 16% da comunidade de pastagens temperadas e prados alpinos, respectivamente. Muitos dos Chloroflexi presentes nestes ambientes formam linhagens muito ramificadas não relacionadas a quaisquer cepas isoladas de Chloroflexi [23].
- Membros do gênero Dehalococcoides foram encontrados para "desclorar" uma ampla gama de contaminantes orgânicos persistentes e, como parte de consórcios mistos, acredita-se que espécies semelhantes a Dehalococcoides sejam promissoras para aplicações de biorremediação [24, 25, 26].
- Filo Chloroflexi isolado Anaerolineae bactéria HOT-439 é dependente de uma cepa auxiliar para o crescimento. Com 12 dias de crescimento: (a) com e (b) sem listras cruzadas F. nucleatum (Figura 1.) [27].
Referências
1. Thompson LR, Sanders JG, McDonald D, Amir A, Ladau J, Locey KJ, et al. A communal catalogue reveals Earth’s multiscale microbial diversity. Nature. 2017;551:457–63. Disponível em: https://www.nature.com/articles/nature24621
2. Delgado-Baquerizo M, Oliverio AM, Brewer TE, Benavent-González A, Eldridge DJ, Bardgett RD, et al. A global atlas of the dominant bacteria found in soil. Science. 2018;359:320–5. Disponível em: https://science.sciencemag.org/content/359/6373/320/tab-figures-data
3. Sunagawa S, Coelho LP, Chaffron S, Kultima JR, Labadie K, Salazar G, et al. Structure and function of the global ocean microbiome. Science. 2015;348:1261359. Disponível em: https://science.sciencemag.org/content/348/6237/1261359.summary
4. Mehrshad M, Salcher MM, Okazaki Y, Nakano S, Šimek K, Andrei A-S, et al. Hidden in plain sight—highly abundant and diverse planktonic freshwater Chloroflexi. Microbiome. 2018;6:176. Disponível em: https://microbiomejournal.biomedcentral.com/articles/10.1186/s40168-018-0563-8
5. Whitman WB. Bergey’s manual of systematics of Archaea and Bacteria. Wiley Online Library; New York, United States, 2015. Disponível em: https://onlinelibrary.wiley.com/doi/book/10.1002/9781118960608
6. χλωρός. Liddell, Henry George; Scott, Robert; A Greek–English Lexicon at the Perseus Project
7. Lewis, Charlton T. and Charles Short, A Latin Dictionary. Oxford: Clarendon Press, 1879.Online version at Perseus
8. Don J. Brenner; Noel R. Krieg; James T. Staley (July 26, 2005) [1984(Williams & Wilkins)]. George M. Garrity (ed.). Introductory Essays. Bergey's Manual of Systematic Bacteriology. 2a (2nd ed.). New York: Springer. p. 304. ISBN 978-0-387-24143-2. British Library no. GBA561951.
9. Gupta RS, Chander P, George S (2013). "Phylogenetic framework and molecular signatures for the class Chloroflexia and its different clades; proposal for division of the class Chloroflexia class. nov. [corrigido] into the suborder Chloroflexineae subord. nov., consisting of the emended family Oscillochloridaceae and the family Chloroflexaceae fam. nov., and the suborder Roseiflexineae subord. nov., containing the family Roseiflexaceae fam. nov". Antonie van Leeuwenhoek. 103(1): 99–119.1589. Disponível em: https://www.ncbi.nlm.nih.gov/pubmed/22903492
10. Rokas, A.; Holland, P. W. (2000). "Rare genomic changes as a tool for phylogenetics". Trends in Ecology & Evolution. 15 (11): 454–459. doi:10.1016/S0169-5347(00)01967-4. Disponível em: https://www.ncbi.nlm.nih.gov/pubmed/11050348
11. Gupta, R. S.; Griffiths, E. (2002). "Critical issues in bacterial phylogeny". Theoretical Population Biology. 61 (4): 423–434. doi:10.1006/tpbi.2002.1589. Disponível em: https://www.ncbi.nlm.nih.gov/pubmed/12167362.
12. Hanada S, Pierson BK (2006) The Family Chloroflexaceae. In: The prokaryotes: a handbook on the biology of bacteria, pp. 815–842. Eds Dworkin M, Falkow S, Rosenberg E, Schleifer KH, Stackebrandt E Springer-: New York.
13. Pierson BK, Castenholz RW (1992) The Family Chloroflexaceae. In: The prokaryotes, pp. 3754–3775. Eds Balows A, Truper HG, Dworkin M, Harder W, Schleifer KH Springer-: New York.
14. Stolz, F. M.; Hansmann, I. (1990). "An MspI RFLP detected by probe pFMS76 D20S23 isolated from a flow-sorted chromosome 20-specific DNA library". Nucleic Acids Research. 18 (7): 1929. doi:10.1093/nar/18.7.1929. Disponível em: https://www.ncbi.nlm.nih.gov/pmc/articles/PMC330654/
15. J.P. Euzéby. "Chloroflexi". List of Prokaryotic names with Standing in Nomenclature(LPSN). Disponível em: http://www.bacterio.net/-classifphyla.html#Chlorobi
16. Sayers; et al. "Chloroflexi". National Center for Biotechnology Information (NCBI) taxonomy database. Disponível em: https://www.ncbi.nlm.nih.gov/Taxonomy/Browser/wwwtax.cgi?mode=Undef&id=200795&lvl=6&lin
17. Yamada, T.; Sekiguchi, Y.; Hanada, S.; Imachi, H.; Ohashi, A.; Harada, H.; Kamagata, Y. (2006). "Anaerolinea thermolimosa sp. nov., Levilinea saccharolytica gen. nov., sp. nov. And Leptolinea tardivitalis gen. nov., sp. nov., novel filamentous anaerobes, and description of the new classes Anaerolineae classis nov. And Caldilineae classis nov. In the bacterial phylum Chloroflexi". International Journal of Systematic and Evolutionary Microbiology. 56 (6): 1331–1340. Disponível em: https://www.ncbi.nlm.nih.gov/pubmed/16738111
18. Yamada, T.; Imachi, H.; Ohashi, A.; Harada, H.; Hanada, S.; Kamagata, Y.; Sekiguchi, Y. (2007). "Bellilinea caldifistulae gen. nov., sp. nov. And Longilinea arvoryzae gen. nov., sp. nov., strictly anaerobic, filamentous bacteria of the phylum Chloroflexi isolated from methanogenic propionate-degrading consortia". International Journal of Systematic and Evolutionary Microbiology. 57 (10): 2299–2306.
Disponível em: https://www.ncbi.nlm.nih.gov/pubmed/17911301
19. Sekiguchi, Y.; Yamada, T.; Hanada, S.; Ohashi, A.; Harada, H.; Kamagata, Y. (2003). "Anaerolinea thermophila gen. nov., sp. nov. And Caldilinea aerophilagen. nov., sp. nov., novel filamentous thermophiles that represent a previously uncultured lineage of the domain Bacteria at the subphylum level". International Journal of Systematic and Evolutionary Microbiology. 53 (6): 1843–1851. Disponível em: https://www.ncbi.nlm.nih.gov/pubmed/14657113
20. Gupta RS, Chander P, George S (2013). "Phylogenetic framework and molecular signatures for the class Chloroflexia and its different clades; proposal for division of the class Chloroflexia class. nov. [corrected] into the suborder Chloroflexineae subord. nov., consisting of the emended family Oscillochloridaceae and the family Chloroflexaceae fam. nov., and the suborder Roseiflexineae subord. nov., containing the family Roseiflexaceae fam. nov". Antonie van Leeuwenhoek. 103 (1): 99–119. doi:10.1007/s10482-012-9790-3. Disponível em: https://www.ncbi.nlm.nih.gov/pubmed/22903492
21. Cole JK, Gieler BA, Heisler DL, Palisoc MM, Williams AJ, Dohnalkova AC, Ming H, Yu TT, Dodsworth JA, Li WJ, Hedlund BP (2013). "Kallotenue papyrolyticum gen. nov., sp. nov., a cellulolytic and filamentous thermophile that represents a novel lineage (Kallotenuales ord. nov., Kallotenuaceae fam. nov.) within the class Chloroflexia". Int J Syst Evol Microbiol. 63 (Pt 12): 4675–82. doi:10.1099/ijs.0.053348-0. Disponível em: https://www.ncbi.nlm.nih.gov/pubmed/23950149
22. Classification of Chloroflexi entry in LPSN. "List of Bacterial Names with Standing in Nomenclature: a folder available on the Internet". Int J Syst Bacteriol. Microbiology Society. 47 (2): 590–2. Disponível em: https://www.ncbi.nlm.nih.gov/pubmed/9103655
23. Krzmarzick M. J. , Crary B. B. , Harding J. J. , Oyerinde O. O. , Leri A. C. , Myneni S. C. , Novak P. J. . ( 2012; ). Natural niche for organohalide-respiring Chloroflexi. . Appl Environ Microbiol 78:, 393––401. Disponível em: https://aem.asm.org/content/aem/78/2/393.full.pdf.
24. Adrian L, Szewzyk U, Wecke J, Görisch H. 2000. Bacterial dehalorespiration with chlorinated benzenes. Nature 408:580 –583. Disponível em: https://www.nature.com/articles/35046063
25. Fennell DE, Nijenhuis I, Wilson SF, Zinder SH, Häggblom MM. 2004. Dehalococcoides ethenogenes strain 195 reductively dechlorinates diverse chlorinated aromatic pollutants. Environ. Sci. Technol. 38:2075–2081. Disponível em: https://pubs.acs.org/doi/10.1021/es034989b
26. He J, Sung Y, Krajmalnik-Brown R, Ritalahti km, Löffler FE. 2005. Isolation and characterization of Dehalococcoides sp. strain FL2, a trichloroethene (TCE)- and 1,2-dichloroethene-respiring anaerobe. Environ. Microbiol. 7:1442–1450. Disponível em: https://www.ncbi.nlm.nih.gov/pubmed/16104866
27. Vartoukian S R, Adamowska A, Lawlor M et al. In Vitro Cultivation of 'Unculturable' Oral Bacteria, Facilitated by Community Culture and Media Supplementation with Siderophores. PLoS One 2016; Jan 14;11(1):e0146926. Disponível em: https://www.ncbi.nlm.nih.gov/pubmed/26764907
28. Holland L. (22 May 1990). "Woese,Carl in the forefront of bacterial evolution revolution". Scientist. 4 (10)
29. Woese, C. R. (1987). "Bacterial evolution". Microbiological Reviews. 51 (2): 221–271. Disponível em: https://www.ncbi.nlm.nih.gov/pubmed/2439888
30. Don J. Brenner; Noel R. Krieg; James T. Staley (July 26, 2005) [1984(Williams & Wilkins)]. George M. Garrity, ed. Introductory Essays. Bergey's Manual of Systematic Bacteriology. (2nd ed.). New York: Springer. p. 304. ISBN 978-0-387-24143-2. British Library no. GBA561951.
31. Bacterial classification entry in LPSN "List of Bacterial Names with Standing in Nomenclature: a folder available on the Internet". Int J Syst Bacteriol. 47 (2): 590–2. Disponível em: https://www.ncbi.nlm.nih.gov/pubmed/9103655
32. Hugenholtz, P.; Stackebrandt, E. (2004). "Reclassification of Sphaerobacter thermophilus from the subclass Sphaerobacteridae in the phylum Actinobacteria to the class Thermomicrobia (emended description) in the phylum Chloroflexi (emended description)". International Journal of Systematic and Evolutionary Microbiology. 54 (6): 2049–2051. Disponível em: https://www.ncbi.nlm.nih.gov/pubmed/15545432
33. Maymo-Gatell, X.; Chien, Y.; Gossett, J. M.; Zinder, S. H. (1997). "Isolation of a Bacterium That Reductively Dechlorinates Tetrachloroethene to Ethene". Science. 276(5318): 1568–1571. Disponível em: https://www.ncbi.nlm.nih.gov/pubmed/9171062
34. Moe, W. M.; Yan, J.; Nobre, M. F.; Da Costa, M. S.; Rainey, F. A. (2009). "Dehalogenimonas lykanthroporepellens gen. nov., sp. nov., a reductively dehalogenating bacterium isolated from chlorinated solvent-contaminated groundwater". International Journal of Systematic and Evolutionary Microbiology. 59 (11): 2692–2697. Disponível em: https://www.ncbi.nlm.nih.gov/pubmed/19625421